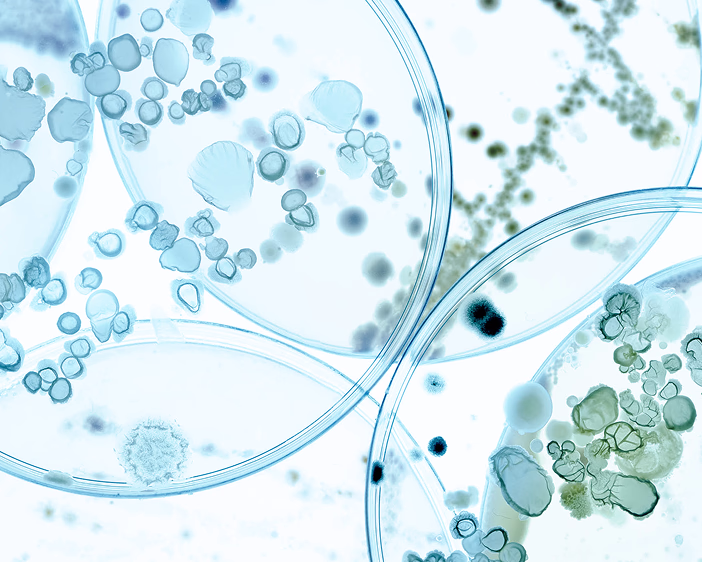

Почему витамины не работают
Витамины — наши друзья в борьбе за крепкое здоровье и сильный иммунитет. Но вот парадокс: иногда сколько ни пьёшь витаминных добавок, эффекта не чувствуется. Усталость, частые простуды, длительное восстановление после физических нагрузок. Может быть, витамины просто не усваиваются? Попробуем разобраться, почему и какую роль в этом играет наша микрофлора.